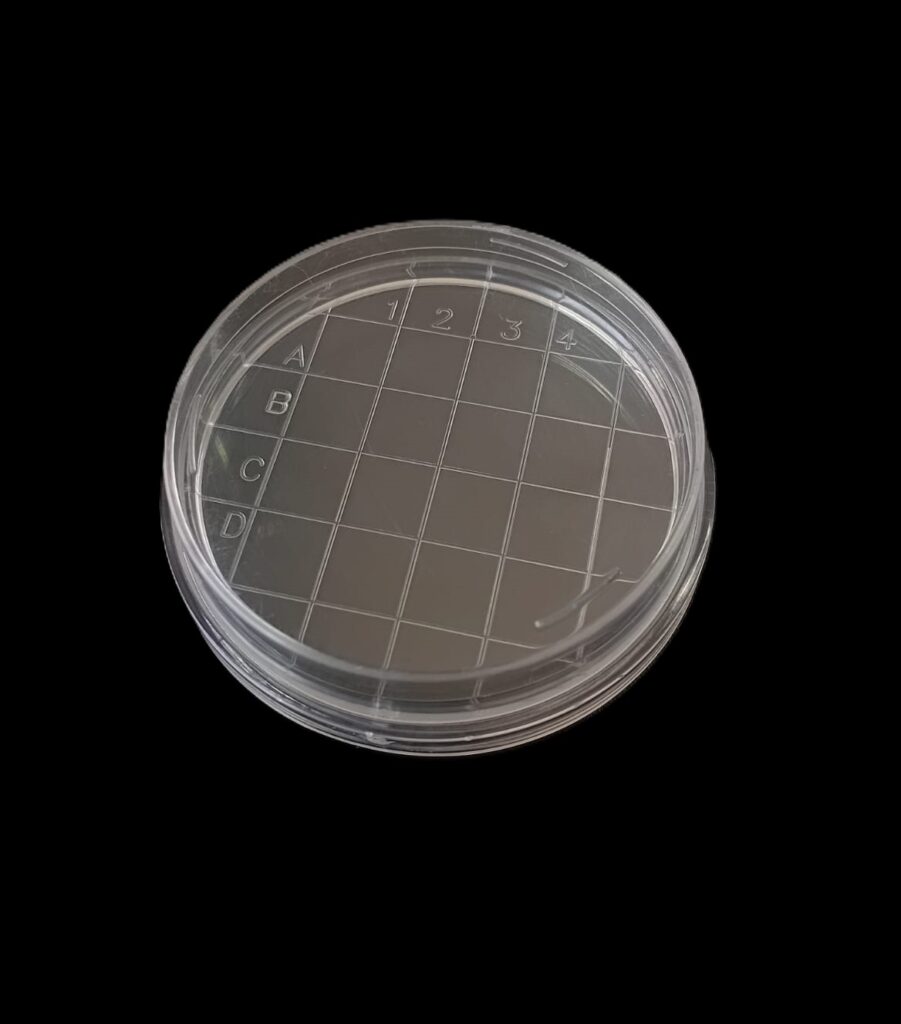

| Código: | 1850106 IA |
| Caja cerrada: | 50 |
| Venta mínima / Presentación: | 50 |
INFORMACIÓN DETALLADA:
Crioperlas MIX de colores. Cada vial contiene una solución de crioconservación y perlas previamente tratadas con su superficie modificada. El sistema está diseñado para facilitar el manejo de las muestras conservadas a bajas temperaturas (-80°C -130°C), minimizar contaminaciones y repetidos ciclos de descongelado. El sistema es apto para conservar bacterias gran negativas, gran positivas y algunos tipos de levaduras, a partir de medios líquidos o colonias aisladas. No es apto para conservar células de mamíferos ni de insectos .El sistema contiene perlas suficientes para realizar 50 cultivos líquidos. LA CAJA POSEE DIEZ VIALES DE CADA COLOR
Se puede solicitar caja x 50 viales de un solo color. Consultar los colores disponibles: Amarillo, Verde, Rojo, Azul, Rosa

| Código: | 785TYA16 CH |
| Caja cerrada: | 500 |
| Venta mínima / Presentación: | 20 |
INFORMACIÓN DETALLADA:
Placas de PCR 96 pocillos de polipropileno flexible autoclavable. Las placas poseen identificación alfanumérica grabada de molde. Apta para la mayoría de termocicladores, incluyendo aquellos de tiempo real. Placa de paredes finas para una excelente transferencia térmica. Al ser de polipropileno flexible se puede cortar fácilmente. Dimensiones según el estándar SBS
Presentados en bolsas con cierre para su mejor almacenamiento. Contenido bolsa: 20 unidades



| Código: | 785TYA16FS CH |
| Caja cerrada: | 30 |
| Venta mínima / Presentación: | 5 |
INFORMACIÓN DETALLADA:
Placas de PCR 96 pocillos Libre de DNAsa, RNAsa y pirógenos de polipropileno flexible autoclavable. Las placas poseen identificación alfanumérica grabada de molde. Apta para la mayoría de termocicladores, incluyendo aquellos de tiempo real. Placa de paredes finas para una excelente transferencia térmica. Al ser de polipropileno flexible se puede cortar fácilmente. Dimensiones según el estándar SBS
Presentados en bolsas con cierre para su mejor almacenamiento. Contenido bolsa: 5 unidades


| Código: | 785TYA17 CH |
| Caja cerrada: | 500 |
| Venta mínima / Presentación: | 20 |
INFORMACIÓN DETALLADA:
Placas de PCR 96 pocillos con borde alto de polipropileno flexible autoclavable. Las placas poseen identificación alfanumérica grabada de molde. Apta para la mayoría de termocicladores, incluyendo aquellos de tiempo real. Placa de paredes finas para una excelente transferencia térmica. Al ser de polipropileno flexible se puede cortar fácilmente. Dimensiones según el estándar SBS
Presentados en bolsas con cierre para su mejor almacenamiento. Contenido bolsa: 20 unidades



| Código: | 785TYE08D CH |
| Caja cerrada: | 200 |
| Venta mínima / Presentación: | 40 |
INFORMACIÓN DETALLADA:
Microtiter 96 wells fondo "U" CON TAPA estéril OE - bolsa por unidad. Placas para microtitracion estériles con tapa, fabricadas en poliestireno de alta transparencia. Las placas de fondo “U” también se utilizan para recuperar la totalidad de la muestra o para separar componentes mediante centrifugación. Medidas tomadas con tapa: 12,8 cm de largo x 8, 5 cm de ancho x 1,8 de alto



| Código: | 785TYE09D CH |
| Caja cerrada: | 200 |
| Venta mínima / Presentación: | 40 |
INFORMACIÓN DETALLADA:
Microtiter 96 wells fondo "V" CON TAPA estéril OE - B/U. Placas para microtitracion estériles con tapa, fabricadas en poliestireno de alta transparencia. Las placas de fondo “V” sirve para recuperar la totalidad de la muestra o bien para separar componentes mediante centrifugación. Pueden utilizarse para la técnica de fijación por complemento. Medidas tomadas con tapa: 12,8 cm de largo x 8, 5 cm de ancho x 1,8 de alto



| Código: | 785TYE10D CH |
| Caja cerrada: | 200 |
| Venta mínima / Presentación: | 40 |
INFORMACIÓN DETALLADA:
Microtiter 96 wells fondo plano CON TAPA estéril OE - B/U. Placas para microtitracion estériles con tapa, fabricadas en poliestireno de alta transparencia. Las placas de fondo plano son las más indicadas para lectura óptica. Son también aptas para el cultivo celular en suspensión, así como para aquellas aplicaciones ELISA en las que no se precise el tratamiento de la superficie para mejorar la adhesión entre la placa y el antígeno o anticuerpo. Medidas tomadas con tapa: 12,8 cm de largo x 8, 5 cm de ancho x 1,8 de alto



| Código: | 785TYE11 CH |
| Caja cerrada: | 50 |
| Venta mínima / Presentación: | 10 |
INFORMACIÓN DETALLADA:
Placas de 24 pocillos para cultivo celular CON TAPA de una sola posicion BOLSA POR UNIDAD. Aptas para todos los instrumentos comunes y automatizados. Envasadas individual PEEL - PACK. TC tratadas, libre de pirogenos, tratadas con radiación gamma
DIMENSIONES: Largo 127,39 mm / Ancho 85,30 mm / Alto 18,21 mm / Diámetro del pocillo 19 mm



| Código: | 785TYE12 CH |
| Caja cerrada: | 50 |
| Venta mínima / Presentación: | 10 |
INFORMACIÓN DETALLADA:
Placas de 12 pocillos para cultivo celular CON TAPA de una sola posicion BOLSA POR UNIDAD. Aptas para todos los instrumentos comunes y automatizados. Envasadas individual PEEL - PACK. TC tratadas, libre de pirogenos, tratadas con radiación gamma.
DIMENSIONES: Largo 127,39 mm / Ancho 85,30 mm / Alto 18,21 mm / Diámetro del pocillo 26 mm



| Código: | 785TYE13 CH |
| Caja cerrada: | 50 |
| Venta mínima / Presentación: | 10 |
INFORMACIÓN DETALLADA:
Placas de 6 pocillos para cultivo celular CON TAPA de una sola posicion BOLSA POR UNIDAD. Aptas para todos los instrumentos comunes y automatizados. Envasadas individual PEEL - PACK. TC tratadas, libre de pirogenos, tratadas con radiación gamma.
DIMENSIONES: Largo 127,39 mm / Ancho 85,30 mm / Alto 18,21 mm / Diámetro del pocillo 35 mm



| Código: | 795TYE14A CH |
| Caja cerrada: | 5000 |
| Venta mínima / Presentación: | 100 |
INFORMACIÓN DETALLADA:
Asas de inoculación plásticas descartables 1 ul estéril por Óxido de Etileno envasadas por 20 unidades PEEL-PACK.
Asas calibradas en poliestireno con flexibilidad para su correcto uso. En uno de los extremos se encuentra la anilla destinada a la siembra, tanto cualitativa como cuantitativa, de placas de Petri, y en el otro extremo, una punta fina especialmente diseñada para el recuento de colonia.
Presentacion individual ver codigo 795TYE14D

| Código: | 795TYE14D CH |
| Caja cerrada: | 5000 |
| Venta mínima / Presentación: | 250 |
INFORMACIÓN DETALLADA:
Asas de inoculación plásticas descartables 1 ul estéril por Óxido de Etileno en envase individual PEEL-PACK. .
Asas calibradas en poliestireno con flexibilidad para su correcto uso. En uno de los extremos se encuentra la anilla destinada a la siembra, tanto cualitativa como cuantitativa, de placas de Petri, y en el otro extremo, una punta fina especialmente diseñada para el recuento de colonia


| Código: | 795TYE15A CH |
| Caja cerrada: | 5000 |
| Venta mínima / Presentación: | 100 |
INFORMACIÓN DETALLADA:
Asas de inoculación plásticas descartables 10 ul estéril OE B/20 PEEL-PACK.
Asas calibradas 10 ul en poliestireno con flexibilidad para su correcto uso. En uno de los extremos se encuentra la anilla destinada a la siembra, tanto cualitativa como cuantitativa, de placas de Petri, y en el otro extremo, una punta fina especialmente diseñada para el recuento de colonia
Presentación en envase individual ver código 795TYE15D


| Código: | 795TYE15D CH |
| Caja cerrada: | 5000 |
| Venta mínima / Presentación: | 250 |
INFORMACIÓN DETALLADA:
Asas de inoculación 10 ul plásticas descartables 10 ul estéril por Óxido de Etileno envase individual PEEL-PACK. . Asas calibradas en poliestireno con flexibilidad para su correcto uso. En uno de los extremos se encuentra la anilla destinada a la siembra, tanto cualitativa como cuantitativa, de placas de Petri, y en el otro extremo, una punta fina especialmente diseñada para el recuento de colonia

| Código: | 795TYE606A CH |
| Caja cerrada: | 5000 |
| Venta mínima / Presentación: | 100 |
INFORMACIÓN DETALLADA:
Asas de inoculación plásticas descartables PUNTA AGUJA 1 ul estéril por Óxido de Etileno en envase por 20 unidades PEEL-PACK. En poliestireno con la flexibilidad necesaria para su correcto uso
Presentacion en envase individual ver código 795TYE606D



| Código: | 795TYE608A CH |
| Caja cerrada: | 5000 |
| Venta mínima / Presentación: | 100 |
INFORMACIÓN DETALLADA:
Asas de inoculación plásticas descartables PUNTA AGUJA 10 ul estéril por Óxido de Etileno en envase por 20 unidades PEEL-PACK. En poliestireno con la flexibilidad necesaria para su correcto uso
Presentación en envase individual ver código 795TYE608D




| Código: | 685TCF025-S CH |
| Caja cerrada: | 50 |
| Venta mínima / Presentación: | 10 |
INFORMACIÓN DETALLADA:
Frascos FLASKS para cultivo celular 25 cm3, superficie tratada. El ángulo del cuello ofrece un buen acceso al frasco, disponibles con y sin ventilación MARCA BIOFIL Libre de DNAsa, RNAsa y pirógenos. Esteril R.GAMMA.
Presentados en bolsas con cierre para su mejor almacenamiento. Contenido bolsa: 10 unidades

| Código: | 685TCF025-V CH |
| Caja cerrada: | 50 |
| Venta mínima / Presentación: | 10 |
INFORMACIÓN DETALLADA:
Frascos FLASKS para cultivo celular 25 cm3, superficie tratada. El ángulo del cuello ofrece un buen acceso al frasco, disponibles con y sin ventilación MARCA BIOFIL Libre de DNAsa, RNAsa y pirógenos. Esteril R.GAMMA.
Presentados en bolsas con cierre para su mejor almacenamiento. Contenido bolsa: 10 unidades

| Código: | 685TCF075-S CH |
| Caja cerrada: | 50 |
| Venta mínima / Presentación: | 5 |
INFORMACIÓN DETALLADA:
Frascos FLASKS para cultivo celular 75 cm3, superficie tratada. El ángulo del cuello ofrece un buen acceso al frasco, disponibles con y sin ventilación MARCA BIOFIL Libre de DNAsa, RNAsa y pirógenos. Esteril R.GAMMA.
Presentados en bolsas con cierre para su mejor almacenamiento. Contenido bolsa: 5 unidades

| Código: | 685TCF075-V CH |
| Caja cerrada: | 50 |
| Venta mínima / Presentación: | 5 |
INFORMACIÓN DETALLADA:
Frascos FLASKS para cultivo celular 75 cm3, superficie tratada. El ángulo del cuello ofrece un buen acceso al frasco, disponibles con y sin ventilación MARCA BIOFIL Libre de DNAsa, RNAsa y pirógenos. Esteril R.GAMMA.
Presentados en bolsas con cierre para su mejor almacenamiento. Contenido bolsa: 5 unidades

| Código: | 685TCF175-S CH |
| Caja cerrada: | 25 |
| Venta mínima / Presentación: | 5 |
INFORMACIÓN DETALLADA:
Frascos FLASKS para cultivo celular 175 cm3, superficie tratada. El ángulo del cuello ofrece un buen acceso al frasco, disponibles con y sin ventilación MARCA BIOFIL Libre de DNAsa, RNAsa y pirógenos. Esteril R.GAMMA.
Presentados en bolsas con cierre para su mejor almacenamiento. Contenido bolsa: 5 unidades

| Código: | 685TCF175-V CH |
| Caja cerrada: | 25 |
| Venta mínima / Presentación: | 5 |
INFORMACIÓN DETALLADA:
Frascos FLASKS para cultivo celular 175 cm3, superficie tratada. El ángulo del cuello ofrece un buen acceso al frasco, disponibles con y sin ventilación MARCA BIOFIL Libre de DNAsa, RNAsa y pirógenos. Esteril R.GAMMA.
Presentados en bolsas con cierre para su mejor almacenamiento. Contenido bolsa: 5 unidades

| Código: | IA |
| Caja cerrada: | Varía segun volumen |
| Venta mínima / Presentación: |
INFORMACIÓN DETALLADA:
Colector PET bocha ancha con rosca contínua. Tratado R. GAMMA. Con faja de seguridad. Entre la tapa y la rosca se encuentra un disco de poliestireno expandido que hace que su cierre sea seguro.
Codigo 6850607 de 250 ml - Caja x 35 unidades
Codigo 6850608 de 500 ml - Caja x 40 unidades

| Código: | 6850610 IA |
| Caja cerrada: | varía segun volumen |
| Venta mínima / Presentación: |
INFORMACIÓN DETALLADA:
Botellas PET tratada R. GAMMA con tapa precinto inviolable
Código 6850610 de 30 ml - Caja x 66 unidades
Código 6850611 de 50 ml - Caja x 50 unidades
Código 6850612 de 100 ml - Caja x 32 unidades
Código 6850613 de 250 ml - Caja x 60 unidades
Código 6850614 de 500 ml - Caja x 40 unidades
Código 6850624 de 1000 ml - Caja x 12 unidades

| Código: | 6850601 IA |
| Caja cerrada: | 12 |
| Venta mínima / Presentación: | 12 |
INFORMACIÓN DETALLADA:
Botella de polietileno baja densidad 1000 ml tapa precinto R. Gamma c/tiosulfato líquido). Botellas con tiosulfato líquido, ideales para el análisis de aguas de consumo humano, piscinas, y aquellas aguas en que la presencia del cloro pueda modificar la composición de la muestra durante el transporte. Etiqueta impresa con espacio para rotulado e información del producto (CODIGO, LOTE Y VENCIMIENTO) - UNICAMENTE A PEDIDO
| Código: | 6850602 IA |
| Caja cerrada: | 35 |
| Venta mínima / Presentación: | 35 |
INFORMACIÓN DETALLADA:
Botella de polietileno baja densidad 500 ml tapa precinto R. Gamma c/tiosulfato (líquido)Botellas con tiosulfato líquido, ideales para el análisis de aguas de consumo humano, piscinas, y aquellas aguas en que la presencia del cloro pueda modificar la composición de la muestra durante el transporte. Etiqueta impresa con espacio para rotulado e información del producto (CODIGO, LOTE Y VENCIMIENTO) - UNICAMENTE A PEDIDO
| Código: | 6850603 IA |
| Caja cerrada: | 12 |
| Venta mínima / Presentación: | 12 |
INFORMACIÓN DETALLADA:
Botella de polietileno baja densidad 1000 ml tapa precinto R. Gamma s/tiosulfato. Botellas estériles, ideales para la recogida de agua no cloradas para el análisis microbiológicas, así como para otros análisis que requieran un envase estéril. Etiqueta impresa con espacio para rotulado e información del producto (CODIGO, LOTE Y VENCIMIENTO) - UNICAMENTE A PEDIDO
| Código: | 6850604 IA |
| Caja cerrada: | 35 |
| Venta mínima / Presentación: | 35 |
INFORMACIÓN DETALLADA:
Botella de polietileno baja densidad 500 ml tapa precinto R. Gamma s/tiosulfato. Botellas estériles, ideales para la recogida de agua no cloradas para el análisis microbiológicas, así como para otros análisis que requieran un envase estéril. Etiqueta impresa con espacio para rotulado e información del producto (CODIGO, LOTE Y VENCIMIENTO) - UNICAMENTE A PEDIDO
| Código: | 6850605 IA |
| Caja cerrada: | 200 |
| Venta mínima / Presentación: | 200 |
INFORMACIÓN DETALLADA:
Frasco roscado 125 ml graduado de molde 57 x 73, ESTERIL A GRANEL Bolsa por unidad. Cuerpo en polipropileno de alta transparencia graduado con banda mate para rotulado y tapa en polietileno color rojo. Tapa a rosca con cierre tipo bayoneta.


| Código: | 6850605AG IA |
| Caja cerrada: | 1000 |
| Venta mínima / Presentación: | 1000 |
INFORMACIÓN DETALLADA:
Frasco de 125 ml grad. de molde 57 x 73. A GRANEL. Presentación frascos y tapa por separado. Frascos roscados tapa roja en polipropileno autoclavable. Cuerpo en polipropileno de alta transparencia y tapa en polietileno color rojo. Tapa a rosca con cierre tipo bayoneta


| Código: | 6850606 IA |
| Caja cerrada: | 400 |
| Venta mínima / Presentación: | 400 |
INFORMACIÓN DETALLADA:
Frasco roscado 60 ml SIN graduar 38 x 70, ESTERIL A GRANEL bolsa por unidad. Frascos roscados tapa roja en polipropileno autoclavable. Cuerpo en polipropileno de alta transparencia y tapa en polietileno color rojo. Tapa a rosca con cierre tipo bayoneta


| Código: | 6850606AG IA |
| Caja cerrada: | 1000 |
| Venta mínima / Presentación: | 1000 |
INFORMACIÓN DETALLADA:
Frasco de 60 ml S/graduar 38 x 70, A GRANEL. Presentación frascos y tapa por separado. Frascos roscados tapa roja en polipropileno autoclavable. Cuerpo en polipropileno de alta transparencia y tapa en polietileno color rojo. Tapa a rosca con cierre tipo bayoneta


| Código: | 685TYF01 CH |
| Caja cerrada: | 1000 |
| Venta mínima / Presentación: | 100 |
INFORMACIÓN DETALLADA:
Frasco apto centrifuga 30 ml graduado con banda mate, a granel. Frascos roscados tapa roja en polipropileno autoclavable. Cuerpo en polipropileno de alta transparencia graduados de molde con banda mate. Tapa con rosca continua



| Código: | 685TYF01-1 CH |
| Caja cerrada: | 1000 |
| Venta mínima / Presentación: | 1000 |
INFORMACIÓN DETALLADA:
Frasco apto centrifuga 30 ml graduado con banda mate, a granel CON ESPATULA. Frascos roscados tapa roja en polipropileno autoclavable. Cuerpo en polipropileno de alta transparencia graduados de molde con banda mate. Tapa con rosca continua



| Código: | 685TYF02 CH |
| Caja cerrada: | 500 |
| Venta mínima / Presentación: | 100 |
INFORMACIÓN DETALLADA:
Frasco 60 ml graduados, a granel. Frascos roscados tapa roja en polipropileno autoclavable. Cuerpo en polipropileno de alta transparencia graduados de molde con banda mate. Tapa con rosca continua.
Disponible estéril por Óxido de Etileno en envase individual, código 685TYF02-1



| Código: | 685TYF02-2 CH |
| Caja cerrada: | 500 |
| Venta mínima / Presentación: | 100 |
INFORMACIÓN DETALLADA:
Frasco 60 ml graduados, a granel CON ESPÁTULA. Frascos roscados tapa roja en polipropileno autoclavable. Cuerpo en polipropileno de alta transparencia graduados de molde con banda mate. Tapa con rosca continua



| Código: | 685TYF-20 CH |
| Caja cerrada: | 1000 |
| Venta mínima / Presentación: | 100 |
INFORMACIÓN DETALLADA:
Frasco de seguridad, DOBLE CIERRE de 20 ml polipropileno ultra claro autoclavable con tapa color verde en polietileno. Graduación grabada de molde, la base del frasco es estriada para facilitar la manipulación con guantes. La tapa también es estriada y con doble cierre que asegura una muy buena hermeticidad



| Código: | 685TYF-40 CH |
| Caja cerrada: | 500 |
| Venta mínima / Presentación: | 100 |
INFORMACIÓN DETALLADA:
Frasco de seguridad, DOBLE CIERRE de 40 ml polipropileno ultra claro autoclavable con tapa color verde en polietileno. Graduación grabada de molde, la base del frasco es estriada para facilitar la manipulación con guantes. La tapa también es estriada y con doble cierre que asegura una muy buena hermeticidad



| Código: | 685TYF-60 CH |
| Caja cerrada: | 500 |
| Venta mínima / Presentación: | 100 |
INFORMACIÓN DETALLADA:
Frasco de seguridad, DOBLE CIERRE de 60 ml polipropileno ultra claro autoclavable con tapa color verde en polietileno. Graduación grabada de molde, la base del frasco es estriada para facilitar la manipulación con guantes. La tapa también es estriada y con doble cierre que asegura una muy buena hermeticidad



| Código: | 685TYF-90 CH |
| Caja cerrada: | 400 |
| Venta mínima / Presentación: | 50 |
INFORMACIÓN DETALLADA:
Frasco de seguridad, DOBLE CIERRE de 90 ml polipropileno ultra claro autoclavable con tapa color verde en polietileno. Graduación grabada de molde, la base del frasco es estriada para facilitar la manipulación con guantes. La tapa también es estriada y con doble cierre que asegura una muy buena hermeticidad



| Código: | 685TYF-120 CH |
| Caja cerrada: | 300 |
| Venta mínima / Presentación: | 50 |
INFORMACIÓN DETALLADA:
Frasco de seguridad, DOBLE CIERRE de 120 ml polipropileno ultra claro autoclavable con tapa color verde en polietileno. Graduación grabada de molde, la base del frasco es estriada para facilitar la manipulación con guantes. La tapa también es estriada y con doble cierre que asegura una muy buena hermeticidad



| Código: | 685TYF-250 CH |
| Caja cerrada: | 200 |
| Venta mínima / Presentación: | 50 |
INFORMACIÓN DETALLADA:
Frasco de seguridad, DOBLE CIERRE de 250 ml polipropileno ultra claro autoclavable con tapa color verde en polietileno. Graduación grabada de molde, la base del frasco es estriada para facilitar la manipulación con guantes. La tapa también es estriada y con doble cierre que asegura una muy buena hermeticidad